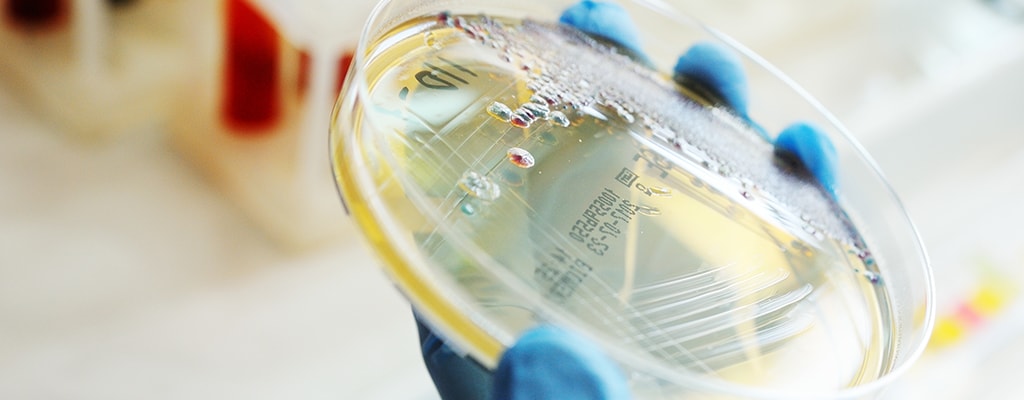
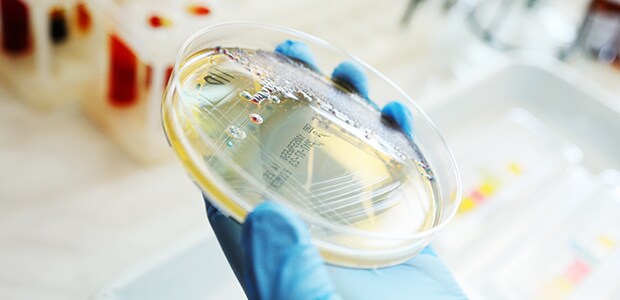

白皮书
医疗侵入式压力传感器的安全注意事项
侵入式压力传感器在患者护理中的应用越来越多。全世界每年使用数十万个一次性侵入式传感器来测量颅骨和心脏的压力。

随着传感器技术的改进,正在开发新的设备,以解决一系列其他适应证。压力感应在许多医疗情况下的好处是众所周知的,但新用户也必须关注在解剖学中引入新技术可能产生的不利影响。本文介绍了生物相容性安全标准和体内使用电流的安全界限,并说明了满足这两种标准的方法。
侵入式压力传感器在患者护理中的应用越来越多。全世界每年使用数十万个一次性侵入式传感器来测量颅骨和心脏的压力。随着传感器技术的改进,正在开发新的设备,以解决一系列其他适应证。压力感应在许多医疗情况下的好处是众所周知的,但新用户也必须关注在解剖学中引入新技术可能产生的不利影响。
侵入式压力传感器目前主要应用于三种应用:
- 在一个称为血流储备分数或 FFR1 的过程中测量冠状动脉中的限制
- 测量颅内压力,或颅内压力监测
- 肺动脉测量以监测心力衰竭。
随着这些传感器更易于使用,其他应用正在开发中。目前最常用的传感器是 MEMS 传感器,它由硅制成,利用惠斯通电桥原理。该传感器本质上是一块有薄硅膜的硅片。压力的变化会导致膜偏转,进而产生与膜上压力成正比的小电压。
信号处理通常用于滤除电噪声,并补偿温度变化,这也会影响传感器的输出。这些传感器通常安装在导丝、导管、内窥镜或其他功能齐全的医疗设备中。

首先,好消息是:由于装配技术的进步,在导管和内窥镜中增加压力传感功能已变得更加简单。然而,当医疗设备设计人员使用体内传感器处理新的治疗方案时,需要对每种新技术的安全性执行评估。提供指导:已发布多项标准,以最大限度地降低将新医疗设备引入人体的风险。
本文重点介绍生物相容性标准 ISO 10993、电气安全标准 IEC 60601-1 和灭菌标准 ISO 11135。这三种标准都与专用于体内的电动传感器相关。体内压力传感器不是成品医疗设备,而是可以安装在许多不同设备中的元件,用于许多不同的最终用途和环境。
元件制造商的一个目标是尽可能降低最终设备供应商使用其元件的风险。元件供应商只能提供有关元件设计产生的已知风险信息,以及为降低风险而采取的步骤;最终,最终医疗设备的性能取决于医疗设备供应商。但是,通过前期元件级别的降低风险活动,设备制造商和患者都能从中受益。
本文列出了体内压力传感器的一些已知或潜在风险,并提出了一些降低风险的措施。

生物相容性
“生物相容性”一词是一个较新的概念,首个定义在 1985 年确定:“材料在特定应用中引起适当的宿主反应的能力。也许这个定义最重要的部分是承认没有生物相容性材料;只有适合特定用途的材料或材料组合(设备)。
人体善于排斥异物,医疗设备设计人员必须注意不要引起人体有害的防御反应,或因物理或化学不相容而造成细胞损伤。ISO 10993-1 最近进行了更新,包含了基于风险的生物相容性测试方法。这意味着每个设备制造商必须评估其特定设备和用例的相应风险,并最大程度地降低这些风险。
新标准旨在消除以完成指标为导向的思维方式,代之以深思熟虑的方法,以提高患者安全性。10993-1 可用于降低压力传感元件的风险。虽然该标准没有描述任何特定的测试,但它确实为选择最适合预期应用的测试提供了指南。并非所有生物相容性测试都与侵入式压力传感器相关。下面,我们列出了一些很可能对设备设计人员有意义的测试。此列表假定该设备将用于循环血液中;浸入其他体液(如尿液或脑脊液)中的设备可能有一套较低的要求。在 ISO 标准中,血液相容性的五个类别被归纳到 ISO 10993-410 中。
我们要讨论的第一个性质是血浆的凝固趋势。这不仅是元件结构中使用的材料的性质,也是其形状的性质。一般来说,任何阻碍血液自由流动的形状都可能导致血液凝固。ASTM F2382-18 描述了一个常见的体外测试。该测试确定暴露于测试设备的柠檬酸化的人类血浆在暴露于磷脂颗粒和氯化钙悬浮液时凝固所需的时间。如果已知凝固时间,则设备设计人员知道其特定应用的时间上限,或者知道在设计中必须采取特殊步骤以防止传感器与血液接触。例如,该传感器可以嵌入柔软光滑的硅胶或氟硅橡胶插头中;这样传感器可正常运行且避免了血液接触到传感器本身,接触血液的是光滑(而不是尖角)外形。SC5b-9 补体激活测定是确定细胞损伤的第二种间接方法。
还应尽可能避免尖角,不仅是因为尖角会让血液凝固,也是为了防止意外切割组织。同样,虽然最终的医疗设备在设计时必须考虑到血液相容性,但对于设备设计人员来说,知道元件本身不会增加风险是有用的。ISO 10993-511 中涉及细胞毒性。细胞毒性化学品或材料是指那些能引起细胞死亡的化学品或材料。该标准参考描述确保有毒化学品不会从医疗设备(以及组成该设备的元件)中溶解出来的方法的测试。在洗脱方法中,设备首先浸泡在细胞生长介质中。
完全指定设备的表面积和浸泡条件,包括时长;到达指定时间后,取出设备。在第二个烧瓶中,将细胞培养在同一类型的介质中。在细胞广泛生长后,将浸泡设备的介质与生长的细胞一起倒入,并检查是否有细胞死亡的证据。ISO 10993-10 指出各种确定致敏性的测试。这些测试旨在降低设备严重、重复或长期暴露于人体免疫系统的风险。
通常对豚鼠执行最大剂量法致敏测试,豚鼠对皮肤接触的免疫反应与人类相似。医疗设备浸泡在液体中形成提取物。给动物注射少量的提取物,两周后在皮肤上贴上贴片;贴片上含有相同的提取物。如果出现发红或肿胀,则将该设备视为一种潜在的过敏原。皮内研究使用类似的提取物,但在这种情况下,初始注射后在皮肤下小剂量注射。这称为皮内研究。最后,ISO 10993-11 旨在降低与医疗设备相关的系统性影响的风险。
该标准参考几种与不同暴露方式(例如吸入、摄入、腹膜和皮下暴露等)对应的测试。每个暴露途径都有一组不同的可能测试方法。这些测试大多数都是使用流浸膏剂(在指定条件下将设备浸泡在液体中),但在某些情况下,设备是被植入的。如果有理由认为设备在体内的严苛环境中会降解,则最常使用植入体。10993-11 中的一个重要部分是致热性测试,用于检测暴露于设备时是否存在发热。
在这些测试中,将提取物注射到兔子体内,然后监测它们的温度数小时。温度持续上升表明设备设计和材料存在致热风险。元件制造商可通过以下方式将风险降至最低:只使用在侵入性医疗设备中具有长期成功使用史的材料来设计元件,并尽可能最大限度地减少血液或其他液体可能积聚和停滞的尖角和区域。这些预防措施将最大限度地减少毒性、炎症、发热和过敏反应以及血栓形成和血液凝固的可能性。如果医疗设备元件符合上述每一项标准,则可量化该设备的能力。它还可以突出显示风险区域。此信息使设计人员以最低风险配置来实施元件。

安全电流限制
大多数市售的压力传感器由电流供电,并以电压变化的形式提供信号。人们怀疑低至 50uA 的电流可能引起心律失常;出于道德和实际原因,确切的数值仍然未知。与将电流引入体内有关的危害构成第二类风险。同样,还制定了全球公认的标准,以指导元件和设备制造商。
遵循 ANSI/AAMI ES1 可保护患者在诊断过程中免于受到暴露于电流的潜在伤害。此标准承认,在正常操作期间,通过液体或组织接触,可能会从供电设备泄漏出一定量的电流。它还承认设备可能以各种方式出现故障,并对患者因任何单点故障而暴露的电流量进行了限制。
为了防止患者受伤,该标准将患者在正常操作期间可暴露于的电流量上限设置为 10uA,在所有单点故障模式下可暴露于的电流量上限设置为 50uA。该标准不适用于治疗程序,例如,可能故意引入电流以消融或刺激组织。
为了简化医疗设备制造商的设计,元件制造商可以确保其元件符合此标准。如果元件本身不会违反该标准,则最终设备设计人员不需要进行任何特殊调整来确保最终设备也符合此标准。一种方式是使用基于光纤的传感器,其中完全不引入电流。使用法布里-珀罗干涉仪的光纤传感器完全符合 ISO 60601-1 标准,并且不受电气干扰。然而,由于缺乏大批量生产方法和对曲率半径的担忧,阻碍了它们的广泛采用。
对于电动传感器,元件设计者可以采用的一个策略是让他们的设备在电流低于 10uA 的情况下工作,此外,确保任何单个元件出现故障时,通过设备的电流小于 50uA。下面我们将根据压力传感器讨论此策略。通常情况下,市售传感器的工作电压为 1.8 至 5.0 伏特,且电阻在 800 至 5000 欧姆范围内。这导致工作电流在 360uA 至 6.25mA 范围内,远远超出 ISO 60601-1 的要求。
体内使用需要采用其他方法。最近的一种方法是使用一系列限流电阻器将电流保持在 10uA 以下,并结合电路元件来提高信噪比。连接到传感器输出的放大器电路可有效地将流经传感器的电流降至零;进而,此无效电路可用于测量压力。实验结果表明,在正常工作时,实际电流保持在 8uA 以下。该电路设计为使任何单个元件的故障或任何两个点之间的桥接仍保持低于 50uA 的电流,这也符合标准。尽管电流低,但经实验确定 RMS 噪声在 24Hz 数据采集速率下小于 0.14uV,从而确保可接受的信噪比。

灭菌
根据 ISO,无菌设备是指一种不含活性微生物的设备。由于可能难以检测是否完全没有生物体,更不用说实现完全没有生物体的情况,因此此定义被修正为存在活的微生物的几率低于百万分之一。
目前,有三种主要的灭菌途径:
- 蒸汽(高压灭菌器)
- 有毒气体(环氧乙烷、过氧化氢、臭氧)
- 辐射(电子束、伽马射线或 X 射线)
对于能够承受蒸汽灭菌的材料来说,蒸汽灭菌是最常用的方法,因为它无毒、廉价且可靠。ISO 1766521 中介绍了正确的程序。加压蒸汽既能杀灭微生物,又能杀灭孢子。然而,虽然蒸汽灭菌是钢制手术元件的理想选择,但使用粘合剂、塑料和/或橡胶密封件的复杂设备通常会被高压灭菌过程损坏或破坏。体内使用的压力传感器可能含有环氧树脂或聚硅氧烷基密封剂,这两种密封剂都不能承受高可靠性的高压灭菌。读者可参阅 ISO 1766521,了解关于公认方法的完整描述。

环氧乙烷气体 (ETO) 的优点是,它不会破坏医疗设备中使用的大多数材料,而且它具有足够的穿透力,甚至可用于对已经包装在包装中的设备进行灭菌。它也有缺点:具有爆炸性和易燃性,对医院工作人员和环境都有潜在危险。它还需要 1 至 6 小时的循环时间,湿度控制在 40% 至 60% 之间,温度控制在 37°C 至 63°C 之间;这些都会增加该流程的额外成本。
ISO ANSI 11135:2014 描述了用于确保环氧乙烷气体安全有效使用的具体协议。首先,元件(及其任何
包装)必须暴露在温度为 47°C、相对湿度为 65% 的环境中 12 到 72 小时,具体取决于尺寸。设备必须能够承受高真空,
因为需要真空来引入 ETO 气体,从而避免与空气混合带来爆炸风险。此外,通过分几个阶段抽真空
和回填氮气来清除气体,以确保彻底清除气体至 65ppm 以下的水平。
辐射是一种昂贵但有效的医疗设备灭菌方法。使用受核管理委员会严格监管的源材料的
伽马射线辐射是最常用的商用级流程。它可以穿透多层材料和包装,其有效性对
湿度、温度或压力不敏感。某些塑料、粘合剂和橡胶也会因暴露于电离辐射而脆化。ISO 11137 包括几个章节,描述了建立和保持医疗设备安全有效的灭菌方法的已批准方法。
有效的剂量测定是该流程的关键部分,既可确保适当的灭菌,又可防止对操作人员造成伤害。元件制造商可证明其元件在暴露于一种或多种 FDA 批准的灭菌方法后继续正常工作,从而帮助设备制造商将风险降到最低。了解这些方法引起的性能风险可以指导最终设备的灭菌决策,并避免错误导致的重大损失。
环氧乙烷气体 (ETO) 的优点是,它不会破坏医疗设备中使用的大多数材料,而且它具有足够的穿透力,甚至可用于对已经包装在包装中的设备进行灭菌。它也有缺点:具有爆炸性和易燃性,对医院工作人员和环境都有潜在危险。它还需要 1 至 6 小时的循环时间,湿度控制在 40% 至 60% 之间,温度控制在 37°C 至 63°C 之间;这些都会增加该流程的额外成本。ISO ANSI 11135:2014 描述了用于确保环氧乙烷气体安全有效使用的具体协议。首先,元件(及其任何包装)必须暴露在温度为 47°C、相对湿度为 65% 的环境中 12 到 72 小时,具体取决于尺寸。设备必须能够承受高真空,因为需要真空来引入 ETO 气体,从而避免与空气混合带来爆炸风险。此外,通过分几个阶段抽真空和回填氮气来清除气体,以确保彻底清除气体至 65ppm 以下的水平。辐射是一种昂贵但有效的医疗设备灭菌方法。使用受核管理委员会严格监管的源材料的伽马射线辐射是最常用的商用级流程。它可以穿透多层材料和包装,其有效性对湿度、温度或压力不敏感。某些塑料、粘合剂和橡胶也会因暴露于电离辐射而脆化。ISO 11137 包括几个章节,描述了建立和保持医疗设备安全有效的灭菌方法的已批准方法。有效的剂量测定是该流程的关键部分,既可确保适当的灭菌,又可防止对操作人员造成伤害。元件制造商可证明其元件在暴露于一种或多种 FDA 批准的灭菌方法后继续正常工作,从而帮助设备制造商将风险降到最低。了解这些方法引起的性能风险可以指导最终设备的灭菌决策,并避免错误导致的重大损失。

总结
将电动设备引入人体解剖本身就有风险。人体对异物很敏感,消毒不当的设备会将感染深入到关键器官。不受控制的电流会破坏正常的心血管功能。围绕侵入性医疗设备的使用出现一大批法规也就不足为怪了。对于医疗设备工程师来说,设计过程不仅要设计出有效的高性价比设备,还必须对降低风险做出承诺。元件制造商可以通过提供本身已尽可能降低风险的元件来帮助实现这一点。元件和设备制造商可以一起通过精心的产品设计来提高医疗保健标准。



